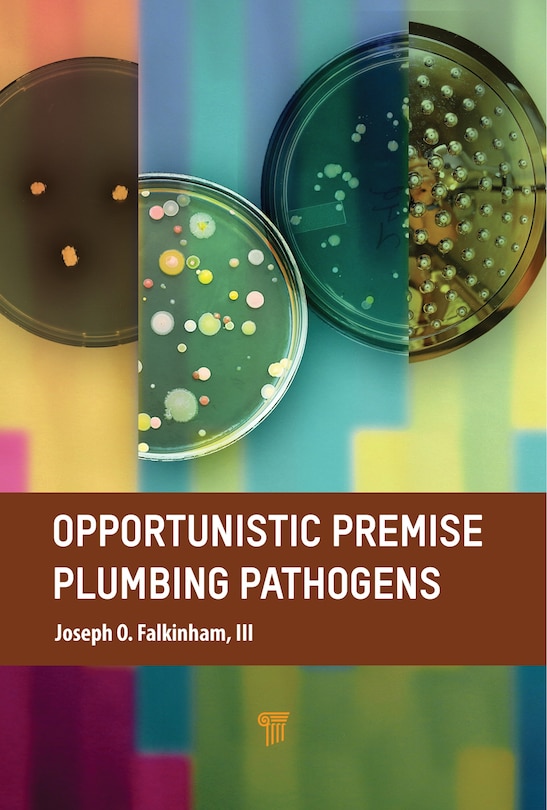
Front cover_Opportunistic Premise Plumbing Pathogens

Free Preview of Opportunistic Premise Plumbing Pathogens
$221.95
Online pricing. Prices and offers may vary in store.

Ship to me
Checking availability…
Buy now & pick up in store
Checking availability…
Find it in store
Checking availability…
Overview
Publisher: Taylor & Francis
Shipping dimensions: 9" H x 6" W x 1" L
ISBN: 9789814968409
Life stage: null
Ratings & Reviews
Editorial reviews
Others Also Bought
Opportunistic Premise Plumbing Pathogens
/en-ca/opportunistic-premise-plumbing-pathogens/2C0C3907-97F7-4A44-B5C2-D2BB560B16DB.html
2C0C3907-97F7-4A44-B5C2-D2BB560B16DB
Opportunistic Premise Plumbing Pathogens
https://dynamic.indigoimages.ca/v1/books/books/9814968404/1.jpg
221.95
Opportunistic Premise Plumbing Pathogens
https://dynamic.indigoimages.ca/v1/https://cdn.kobo.com/book-images/Images/1730ffc9-a91a-4bbc-9c42-915925247603/300/300/False/image.jpg
210.99